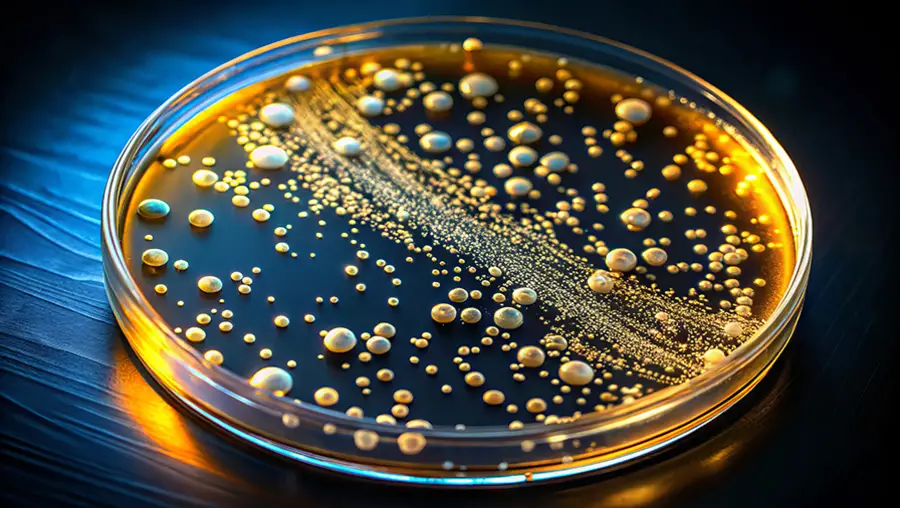

Carnegie Mellon Endowment Stands at $3.2B in 2024
The value of Carnegie Mellon University's endowment stood at $3.2 billion as of June 30.

Tepper School Researcher Advocates for New Framework To Measure Sustainable Economic Growth
In a new study, researchers suggest the need for an integrated framework to assess sustainable economic growth, one that tracks global stocks and flows of natural capital.

Improving Air Quality Would Avoid 80,000 Vet Visits Every Year, Study Finds
New research has found that high levels of air pollution have led to significant increases in the number of vet visits for both cats and dogs.
SCS Researcher Develops Metagenomic Profiling Method
A new k-mer sketching metagenomic profiler allows scientists to analyze genomic data more quickly and precisely than other profilers.

Linking Chemistry With Immune Response To Advance Drug Delivery
By filling in the missing link between lipid chemistry and immune response, Carnegie Mellon professor Kathryn Whitehead is helping to expand the use of lipid nanoparticles beyond RNA vaccines.

Networks of Concepts Demonstrate How Scientific Knowledge Grows
A new study empirically applies philosophical theories to investigate how exactly scientific knowledge grows.

ETC Professor Provides a Practical Education in Horror
CMU's Ruth Comley brings her haunted house experience into her ETC classroom.

Bloody Brilliant: Pre-College Students Learn with Carnegie Mellon Prop Department
Carnegie Mellon University's Pre-College program teaches production techniques including sound, projections, costumes and props — and how to make fake blood.

Radio Telescopes' Earthbound Perspective Clouds Discovery of Fast Radio Bursts
Carnegie Mellon University researchers have discovered that there's not only a bias in how telescopes 'see' but also in how they 'hear.'

Heinz College Announces New Master of Science in Artificial Intelligence Systems Management Program
Carnegie Mellon University has announced a new Master of Science in Artificial Intelligence Systems Management (AIM) program, housed in the Heinz College of Information Systems and Public Policy.

Robert Coury Named William V. Campbell Finalist
Carnegie Mellon University's graduate student inside linebacker Robert Coury is one of 16 finalists for the 2024 William V. Campbell Trophy.

CMU Community Dedicates Highmark Center As a Home For Holistic Student Experience
Carnegie Mellon marks the official opening of the Highmark Center for Health, Wellness and Athletics, a destination for well-being.